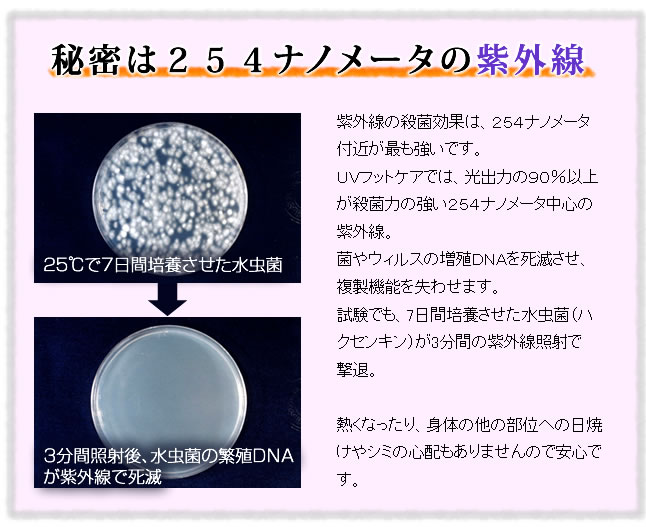
楽天市場】水虫治療器 レビュー150件超 NEW UVフットケア cuv-5 ニュー

NEW UV フットケア Amazon.co.jp: ニュー UVフットケア CUV-5 紫外線治療器 : ビューティー
(3012件)
Pontaパス特典
サンキュー配送
6000円(税込)
60ポイント(1%)
Pontaパス会員ならさらに+1%ポイント還元!
送料
(
)
3002
配送情報
お届け予定日:2026.04.30 14:2までにお届け
※一部地域・離島につきましては、表示のお届け予定日期間内にお届けできない場合があります。
ロットナンバー
19972219942
お買い物の前にチェック!

Pontaパス会員なら
ポイント+1%
ポイント+1%
商品説明


- モデル名: NEW UV フットケア\r- 付属品: サングラス、電源ケーブル\r- 使用方法: 1日1~3分照射\r商品は新品未使用ですがあくまでも自宅保管になりますのでその辺りをご理解していただきまして購入してください。\r箱にはダメージがあります。\rでは、よろしくお願いいたします。
| カテゴリー: | コスメ・美容>>>ボディ・フェイスケア>>>その他 |
|---|---|
| 商品の状態: | 新品、未使用","新品で購入し、一度も使用していない |
| 配送料の負担: | 送料込み(出品者負担) |
| 配送の方法: | 佐川急便/日本郵便 |
| 発送元の地域: | 三重県 |
| 発送までの日数: | 2~3日で発送 |
レビュー
商品の評価:




 4.6点(3012件)
4.6点(3012件)
- ウサギ456
- お安く買えて大変満足しております。次回も機会があればお世話になりたいと思います。
- yuzi98
- 息子の部活用に。 近くの店には12mm幅のテープが売っていなかったので、 助かりました。
- しかおqowop
- 予想通りで、まあいい感じで使っています。
- saaachan0620
- バタフライのラケットケースにあわせて、娘用に購入しました。可愛いし、丈夫そうなので、ガンガン洗濯機で洗っても問題ありません。この価格で良い品物ですので、おすすめです。もうひとつ欲しい
- epponita
- [受注番号]C1605160045 クラブで必要との事で探していたらこの安さで、送料無料!しかも佐川急便ですぐに届きました!大満足です!しかもレビュー書いたらオマケを頂けるとのこと!大大満足です!
- お兄さんその1
- 薄いですが、丈夫そうで使いやすいですよ。 子供用に購入しました。
- jintarosu0223
- 剥がす時に、ラケット板が剥がれないので重宝してます。
すべて見る
お店の情報
7,367
連絡・応対
4.3
配送スピード
4.3
梱包
4.3